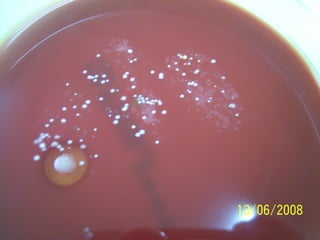
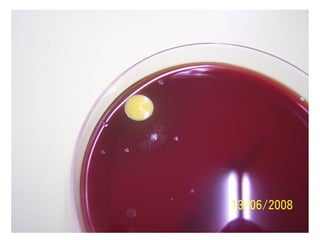

Le document présente différents agents responsables de maladies, notamment les prions, viroïdes, virus, bactéries et protozoaires, ainsi que leurs mécanismes d'infection et les maladies qu'ils provoquent. Il décrit également les cellules du système immunitaire et les types d'immunité, en distinguant l'immunité naturelle, non spécifique, et l'immunité acquise, spécifique. Enfin, les réponses immunitaires et la vaccination sont abordées pour illustrer la défense de l'organisme contre les infections.